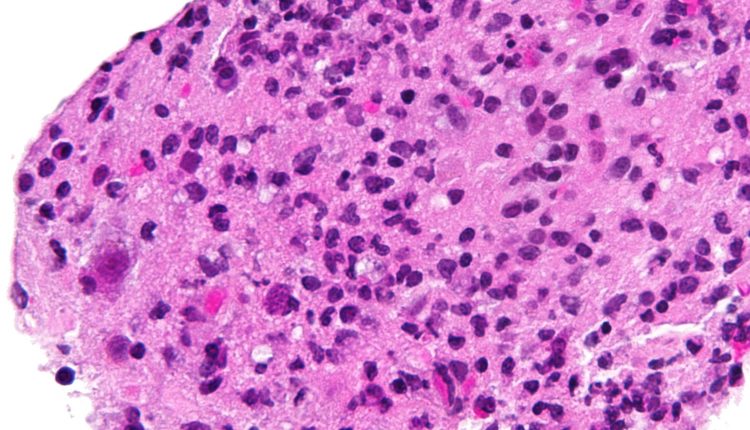
caracteristici Toxoplasmoza

Toxoplasmoza – cat de periculoasa este aceasta afectiune si care sunt complicatiile ei
Orice om isi iubeste prietenul necuvantator pentru ca este loial, dragut si ii tine de urat. Animalele de companie insa pot ascunde multi microbi si pot transmite multe boli printre care si toxoplasmoza
Orice om isi iubeste prietenul necuvantator pentru ca este loial, dragut si ii tine de urat. Animalele de companie insa pot ascunde multi microbi si pot transmite multe boli printre care si toxoplasmoza. Acest parazit, toxoplasma gondi afecteaza jumatate din populatia lumii, gazda principala fiind pisica si gazda intermediara fiind omul.
Toxoplasmoza este, asadar, infectarea cu acest parazit care are simptome specifice menite sa ingrijoreze oamenii purtatori. Toxoplasmoza se poate manifesta prin scaderea acuitatii vizuale, prin inflamarea ganglionilor, febra si poate da chiar afectiuni ce pun viata in pericol persoanelor cu o imunitate scazuta, precum hepatita, miocardita sau encefalita.
Cum se transmite toxoplasmoza?
Prin contact cu fecalele pisicii, prin carnea gatita inadecvat, apa contaminata si transplacentar, de la mama la copil. Unii pacienti cu o imunitate foarte buna infectati cu acest virus nu necesita tratament decat daca le afecteaza acuitatea vizuala. Pot fi facute insa analize medicale in acest sens, iar anticorpii anti Toxoplasma IgG+ trebuie sa puna pe ganduri medicii si pacientii.
Toxoplasmoza poate avea si implicatii destul de periculoase, de la afectarea maculei, afectarea nervului optic, cataracta, pana la glaucom. Cum poate fi prevenita toxoplasmoza? Prin spalarea fructelor si legumelor inainte de a fi consumate, prin evitarea laptelui nepasteurizat sau nefiert, prin prepararea termica adecvata a carnii si prin evitarea curatarii fecalelor de pisica fara manusi. Riscul de transmitere de la mama la fat este foarte mare de aceea tratamentul mamei se face cu Spiramicina.
In sarcina, diagnosticarea mamei cu toxoplasmoza trebuie sa traga un semnal de alarma atat medicului de familie cat si mamei. Desi este o boala foarte raspandita si din ce in ce mai multi oameni sunt infectati, asta nu inseamna ca mama poate sa stea linistita fara a lua masuri in acest sens. Consecintele acestei infectii in timpul sarcinii pot fi observate din pacate la fat daca afectiunea nu este tratata asa cum se cuvine.
In concluzie, chiar si cea mai banala si cea mai des intalnita afectiune in randul oamenilor provocata de un virus transmis de animale trebuie tratata medical in mod corespunzator!